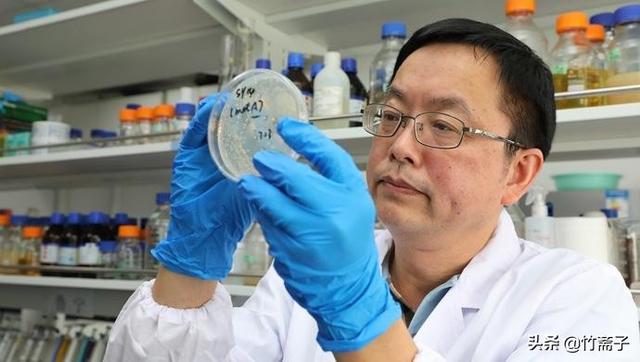
人工合成牛胰岛素获得诺贝尔奖(它是最靠近诺贝尔奖的一次)(1)

人工合成牛胰岛素获得诺贝尔奖(它是最靠近诺贝尔奖的一次)
人工合成牛胰岛素获得诺贝尔奖(它是最靠近诺贝尔奖的一次)
五十年前,一项轰动世界的科研成果问世,它是遥不可及的科学难题,在不断地探索下,我国成功研究出了人工合成牛胰岛素,那么为何说它是距离诺贝尔奖最近的?它为何与诺贝尔奖擦肩而过,今天就跟大家聊一聊。
第一,先立一个小目标
1966年4月,在华沙召开的欧洲生化学会联合会议上,我国的科学家以人工全合成结晶牛胰岛素的科研成果,在国际上引起轰动。
这是我国科学家耗时6年零9个月的成果,是人类历史上首次人工合成牛胰岛素,更是我国距离诺贝尔奖最近的一次。

胰岛素是一个蛋白质的激素,它控制着我们的血糖,如果得了糖尿病,就是胰岛素出现了问题。
胰岛素是临床上用来治疗糖尿病的特效药物,如今去到药店就能买的,便宜又好用。而上个世纪50年代的时候,人工合成胰岛素是一项前所未有的科学高峰,要想攀登,十分困难。
那么,在极端困难的条件下,我国科学家是如何攻克这个科学难题的?
二十世纪五十年代,蛋白质是世界生物化学领域研究的热点。1956年,英国科学家桑格因率先测定了牛胰岛素的化学结构,因此获得了诺贝尔奖。

但牛胰岛素的结构清楚了,却限于当时的科学技术条件,要想人工合成,非常困难。与此同时,英国一位著名科学家在《自然》杂志评论文章中预言:“人工合成胰岛素,还有待于遥远的将来。”
1958年8月,刚刚成立的中国科学院上海生物化学研究所的科研人员提出研究“人工合成牛胰岛素”。
1959年,这项研究成为了国家重大科学技术项目,一开始完成的期限定为20年。而当时是大跃进,属于时代背景特殊,要求进步的青年科学家决定把日期缩短为5年。之后通过研究,国家决定采用大兵团方式进军牛胰岛素的攻破。这就是当时的一个小目标,遥不可及的小目标。

第二,错过诺贝尔奖
一连几个月,三个单位组成的大兵团没有任何进展,其中有些人开始反思,是不是目标订得过大了,于是悲观的情绪渐渐的在研究人员当中萌芽。
然而,就在这个时期,振奋人心的消息出现了。1959年,项目进行的几个月后,由邹承鲁领导的小组首先实现了天然胰岛素的拆合,为人工合成牛胰岛素的研究解决了第一个关键问题。

1960年1月,在全国第一次生化学术会议上,邹承鲁所在小组的年轻科学家杜雨苍,代表全组在会议上发表了,天然牛胰岛素拆合研究的研究成果。这一研究成果一出来,当时就震惊了参与会议的所有人,然而可惜的是,由于当时保密的需要,这个研究成果并没有在国际上发表,就是因为没有公开发表,这个重大的研究成果第一次与诺贝尔奖擦肩而过。
1961年,美国科学家安芬森发表了,与天然胰岛素拆合重结晶类似的,相对而言较为简单的工作,他因此而获得了1972年的诺贝尔化学奖。

初战告捷后,三个单位联合扩招年轻人才,但是由于人数过多,大家相互竞争,浮夸之风盛行,最后使得人工牛胰岛素的研究工作陷入了困境。
之后,又因为三年困难时期,这项工作被停滞了。1964年,国家又重新进行人工牛胰岛素的研究工作。
首先是政策措施的及时更改,人员要求精简,机构不能过多,研究工作需要实事求是。1965年9月3日,在所有人的注视下,杜雨苍将A链和B链进行人工全合成实验,之后冰冻冷藏。十四天后,也就是1965年9月17日这天,人工牛胰岛素化合物成功地出现在众人面前。
随后,研究小组起草论文,将这一重要科学研究成果,以简报形式发表在1965年11月的《中国科学》杂志上,并于1966年4月全文发表。

1966年4月,我国带着人工牛胰岛素研究成果参加了华沙欧洲生化学会,得到了国际同行科学家的承认。
同时,也有许多外国科学家表示,这项研究成果很伟大,可以荣获诺贝尔奖。其中瑞典皇家科学院诺贝尔奖评审委员会化学组主席蒂斯利尤斯教授也表示,这项研究可以荣获诺贝尔奖。

最后,因为种种原因,又让人工牛胰岛素错过了诺贝尔奖。
,

























